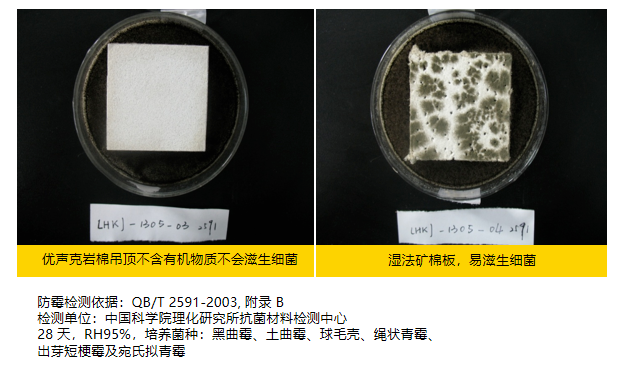

晋强携手实力伙伴,助您打造高品质空间!
2025/12/12

晋强主营产品介绍(二)

相信晋强
相信专业的力量


●
高品质空间打造,离不开靠谱的材料支撑
不管是家居装修、商业办公,还是酒店、学校、医院等公共空间,大家对墙布、墙板、吊顶板的要求越来越高——既要环保安全、耐用省心,又要兼顾美观与实用功能。

上海晋强实业深知这份需求的重要性,携手杜邦、优声克等行业实力伙伴,将优质的墙布、墙板及吸音吊顶板产品引入供应链,凭借自身多年的仓储配送与服务经验,为客户提供贴合实际的材料解决方案。
—— ENP @ SHANGHAI ——

PART.01
杜邦™Tedlar墙布
———— 适配多场景美学需求 ————

想选墙布,既担心甲醛、异味影响健康,又怕日常使用中容易脏、难打理,或是花色用几年就过时、褪色;
不管是家居卧室、儿童房,还是酒店客房、办公空间,都希望墙布能适配空间风格,同时兼顾实用性。





Tedlar®是杜邦公司于20世纪40年代发明的PVF(Polyvinyl Fluoride)材料的注册商标。Tedlar®主要以不同厚度的薄膜形式存在,它可以覆合在多种材料表面形成保护膜。经过几十年的积累、开发,Tedlar®作为饰面保护专家广泛应用于各种室内外场景,具有诸多优势。

防霉抑菌,安全健康
Tedlar®PVF内饰面材不支持霉菌滋长。在医院实验室、治疗室、诊室和患者病房中,面材将提供额外的防污染保护。

经久耐用,持久如新
提供针对大多数染色剂和清洁溶剂的保护性屏障,确保饰面色泽持久如新,非常适合在人流量大的区域使用。

防污耐脏,易于清洁
杜邦™ Tedlar® 内饰面材具有极强的耐化学性,可反复消毒擦洗。可轻松去除各种生活常用污渍以及医用试剂浅留对内饰面的污染。

设计多元,应用广泛
Tedlar®PVF内饰面材可展现不同风格装饰效果,展现细腻凹凸纹理和优雅表面光泽,帮助营造持久耐用,洁净温馨的医养疗愈环境。

杜邦™ Tedlar® 墙面材料以其美观与功能性脱颖而出,能够充分体现洁净空间的设计理念。晋强实业联合杜邦,凭借Tedlar®PVF墙布抗菌、耐擦洗等优势,为多家高端医疗机构带来了全新的空间改造方案。点击链接查看杜邦Tedlar®PVF内饰面材的案例介绍!
PART.02
杜邦实芯理化板
———— 强韧耐腐 ————

实验室里化学试剂洒在台面上瞬间留下腐蚀痕迹,医院诊疗台频繁消毒后表面泛黄磨损,食堂操作台面遇水膨胀变形——这些高频使用、高洁净需求的空间,对台面材料的耐腐、耐磨、环保性提出了严苛要求,普通板材往往用不了多久就需更换。



Tedlar®是杜邦公司于20世纪40年代发明的PVF(Polyvinyl Fluoride)材料的注册商标。Tedlar®主要以不同厚度的薄膜形式存在,它可以覆合在多种材料表面形成保护膜。经过几十年的积累、开发,Tedlar®作为饰面保护专家广泛应用于各种室内外场景,具有诸多优势。


98% 硫酸:5级;40% 氢氟酸:5级
50% 硝酸:5级;37% 盐酸:5级
30% 过氧化氢:5级

180℃ 外观光泽度
瞬时表面无变化

理化板(4.5N)能够防止材料受到外界刮划

气候箱法0.005mg/m3(Enf)级
安全环保,健康放心
上海晋强实业有限公司与全球材料科技巨头杜邦(DuPont)达成深度战略合作,双方依托各自在材料应用与市场服务领域的核心优势,构建起从研发、生产到应用的全链条协作体系。点击链接查看杜邦Tedlar®实芯理化板的案例介绍!
PART.03
优声克岩棉吸音吊顶板
———— 降噪护静 ————

影院观影时后排咳嗽声清晰传到前排,会议室里多人发言时回音缭绕听不清重点,学校教室外的噪音干扰学生听课——这些对声学环境有要求的空间,亟需既能吸音降噪,又兼顾安全、耐用的吊顶材料。尤其是商场、医院等公共区域,还需满足防火、环保的硬性标准。


优声克(Eurocoustic)隶属于全球财富五百强企业之一、世界建材百强排名首位的法国圣戈班。作为设计与生产高性能吸音天花的先驱者,优声克以专业的室内声学矫正、吸音隔音、防火防潮解决方案享誉全球,致力于以一流的产品与服务升级建筑项目舒适度。
天然环保
优声克岩棉取材于火山岩,100%可循环再利用

防火A1等级
优声克岩棉不仅在打造静谧环境、改善室内音质上表现出色,更凭借欧标A级的高防火性能切实保护居住者的人身财产安全

吸音1.0等级
优声克岩棉丝里有很多微孔,声波在里面来回穿梭与摩擦,最后声能转化成热能消耗掉。优声克吊顶NRC 值最低0.9,大部分1.0

防潮抑菌
优声克依靠岩棉材料的高憎水性,保证产品在不同情况下尺寸依旧稳定,尤其在湿度极高的情境中不变形。
2014年,晋强实业携手法国优声克登陆中国高端建材市场,推广岩棉这一新型天然环保材料,受到追求高品质生活及环保人士的关注和推崇。
截至目前,优声克已成功为国内百余个建筑项目提供专业的吸音吊顶解决方案,赢得广大客户的信赖,在业界树立了良好的口碑。


●
高品质空间打造,离不开靠谱的材料支撑
上海晋强实业有幸携手杜邦、优声克等实力伙伴,将他们经过市场检验的优质产品引入服务体系。与此同时,晋强凭借多年仓储、物流和行业经验,帮客户做好选型参考、供货保障等配套服务。不管是家居内饰、功能台面还是吸音吊顶,我们都希望贴合客户的实际需求提供支持。
如果您有相关材料需求,欢迎随时咨询,我们可以提供样品比对和选型建议,尽力帮您对接合适的产品!


